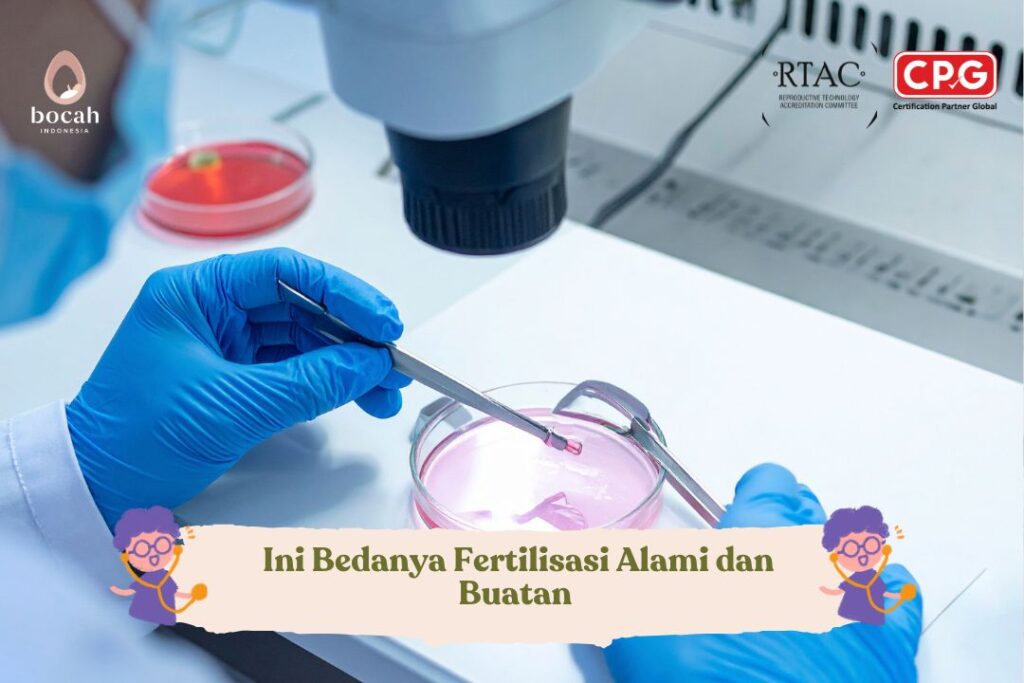

Kanker Prostat : Gejala, Penyebab, Diagnosis, Pengobatan, dan Peluang Hidup
Kanker prostat adalah penyakit serius yang menyerang pria berusia paruh baya atau lebih tua. Kanker prostat umumnya tidak bersifat fatal karena tumbuh lambat. Namun, pengobatan untuk kanker ini dapat memicu gangguan kesuburan.